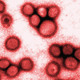
Spanish flu

-
Serbia declares war on Austria-Hungary, quickly leading to the First World War
-
-
US Congress declares war on Germany
-
First observed in south-west Kansas
-
-
Firsrt observed in Queens, New York City
-
Hits North France; West Africa; and Boston, USA.
-
Germany signs Armistice with Allies
-
Another outbreak occurs, but results in fewer deaths
-
Millions have died by this stage
-
No new deaths are reported
A list shows items. A timeline shows sequence.
Use Timetoast to make dates, milestones, and turning points easier to understand in a clear visual format. Timetoast is a timeline maker for work, school, research, and stories.